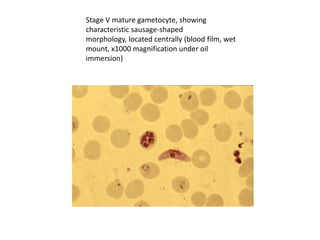
Stage V mature gametocyte, showing
characteristic sausage-shaped
morphology, located centrally (blood film, wet
mount, x1000 magnification under oil
immersion)

This document discusses blood and tissue protozoa, focusing on African trypanosomiasis (sleeping sickness). It describes the etiology, epidemiology, morphology, and life cycle of Trypanosoma brucei, which causes sleeping sickness. The disease has initial stages of a bite reaction, parasitemia, and fever episodes. Later stages involve the central nervous system, causing changes in personality, sleep disturbances, and eventual coma. Diagnosis involves finding the parasite in blood, lymph, or cerebrospinal fluid. Treatment of the blood stage uses pentamidine or suramin, but effective control requires tackling the tsetse fly vector.






























































































![• The malaria parasite life cycle involves two hosts. During a blood meal, a malaria-infected female
Anopheles mosquito inoculates sporozoites into the human host . Sporozoites infect liver cells and
mature into schizonts , which rupture and release merozoites . (Of note, in P. vivax and P. ovale a
dormant stage [hypnozoites] can persist in the liver and cause relapses by invading the bloodstream
weeks, or even years later.) After this initial replication in the liver (exo-erythrocytic schizogony ),
the parasites undergo asexual multiplication in the erythrocytes (erythrocytic schizogony ).
Merozoites infect red blood cells . The ring stage trophozoites mature into schizonts, which rupture
releasing merozoites . Some parasites differentiate into sexual erythrocytic stages (gametocytes)
. Blood stage parasites are responsible for the clinical manifestations of the disease.
The gametocytes, male (microgametocytes) and female (macrogametocytes), are ingested by an
Anopheles mosquito during a blood meal . The parasites’ multiplication in the mosquito is known
as the sporogonic cycle . While in the mosquito's stomach, the microgametes penetrate the
macrogametes generating zygotes . The zygotes in turn become motile and elongated (ookinetes)
which invade the midgut wall of the mosquito where they develop into oocysts . The oocysts grow,
rupture, and release sporozoites , which make their way to the mosquito's salivary
glands. Inoculation of the sporozoites into a new human host perpetuates the malaria life cycle](https://image.slidesharecdn.com/bloodbornprotozoans1-140326032828-phpapp02/85/Blood-born-protozoans-95-320.jpg)

![• Life_cycle_of_malaria_Part_1_Human_hostx.
mp4
• Malaria in the 21st century
x[www.keepvid.com].mp4
• malaria lifecycle x[www.keepvid.com].mp4](https://image.slidesharecdn.com/bloodbornprotozoans1-140326032828-phpapp02/85/Blood-born-protozoans-97-320.jpg)